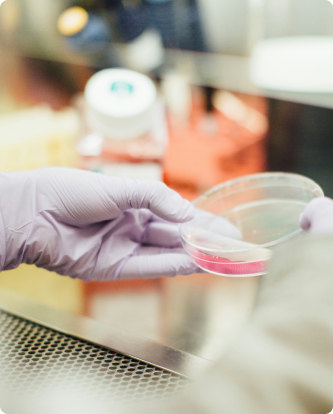

BeyondSpring Pharmaceuticals partnered with Big Drop to give its website a new beginning. The aim was straightforward: build a site that truly tells BeyondSpring’s story, highlights its scientific work, and brings the company’s mission to life for everyone who visits. BeyondSpring’s audience isn’t limited to just investors or partners, clinicians, job seekers, and many others visit as well. The redesigned site needed to reach all of them, meet every compliance requirement, and still come across as modern, reliable, and grounded in real science while positioning BeyondSpring for long-term growth.
BeyondSpring needed to share detailed clinical and scientific info without being over technical with too much jargon. They had to be accurate and stay compliant while adhering to their full audience, not just scientists. Navigation was another challenge to tackle. Every visitor needed a clear way to get straight to what they needed, without tripping over technical terms. Better content flow, smarter audience targeting, and an easy design were all non-negotiable if they wanted people to stick around on the site.


Big Drop overhauled the entire information structure to put BeyondSpring’s science, programs, and story front and center. Now, anyone can quickly find clinical program details, catch up on research news, or get the basics on the company without hassle.
The site finally shows off BeyondSpring’s strengths with a clean, professional look. SEO best practices help people find it, and with WordPress, BeyondSpring’s team can easily make updates as things grow.
Big Drop kicked things off by figuring out what each group of visitors actually cared about. We mapped out which content mattered most and checked how BeyondSpring compared to others in the biopharma world. That research drove new audience journeys for investors, researchers, and partners, while always keeping the science front and center. The plan focused on being clear, credible, and consistent so even the complicated stuff made sense.




The design backs up BeyondSpring’s focus on science and innovation. Simple colors, bold type, and sharp layouts keep things looking polished and confident. Images, icons, and a clear visual hierarchy help make complex topics easy to grasp and build trust as people explore.

User experience led the whole redesign. The new site just feels easier where every audience gets a direct path to what they need. Well-organized content and layouts you can scan in seconds mean even the deep scientific info feels approachable. It’s professional, welcoming, and matches what people expect from a biopharma leader.
No matter what device you’re on, desktop, tablet, or phone, the site works seamlessly across all platforms. Navigation stays steady and everything’s easy to read, so users can engage anywhere, anytime.

Together, Big Drop and BeyondSpring built a digital experience that truly puts BeyondSpring on the map as credible, strong, and ready for what’s next. The new site tells the company’s story better, helps everyone find what they need, and sets up BeyondSpring for its next big steps in science and innovation.
We collaborate with innovative brands to create cutting-edge digital experiences. Let's connect.